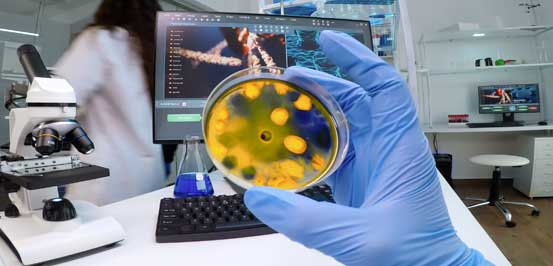

Laboratorio Promociones del mes
La mayoría de las enfermedades se pueden detectar a tiempo con un estudio de laboratorio. Cuida tu salud con chequeos regulares: la prevención es tu mejor tratamiento.
Nosotros te ayudamos a detectar, prevenir y curar enfermedades.
Las 24 hrs los 365 días del año.
Resultados rápidos y precisos, gracias a nuestro equipo calificado y tecnología moderna.
Agenda hoy mismo tu análisis y cuida tu salud.
Conoce algunos de los estudios más comunes que tenemos para ti:

Paquetes Check-Up
Diseñados para ofrecerte una visión completa de tu salud de forma práctica, accesible y confiable.
Diseñados para ofrecerte una visión completa de tu salud de forma práctica, accesible y confiable.
¿Qué incluye? / Enfocado en: Estudios básicos para conocer tu estado general de salud: hemoglobina, glucosa, lípidos, función renal y hepática.
¿Cuándo realizarlo? Una vez al año o al inicio de un nuevo plan de salud o dieta.
¿Qué incluye? / Enfocado en: Incluye todo el Check-Up Mujer + perfil hormonal y tiroideo, ideal para evaluar fertilidad, metabolismo y salud hormonal.
¿Cuándo realizarlo? Cada 6-12 meses, especialmente en mujeres mayores de 30 años o con síntomas hormonales.
¿Qué incluye? / Enfocado en: Evalúa parámetros generales: glucosa, colesterol, función renal y hepática, y niveles de ácido úrico.
¿Cuándo realizarlo? Una vez al año, como control preventivo.
¿Qué incluye? / Enfocado en: Incluye todo el Check-Up Hombre + Antígeno Prostático Específico (PSA) y perfil hormonal masculino.
¿Cuándo realizarlo? A partir de los 40 años oen casos de antecedentes familiares de enfermedades prostáticas o metabólicas.
¿Qué incluye? / Enfocado en: Paquete diseñado para evaluar el estado general antes de una cirugía.
¿Cuándo realizarlo? Previo a cualquier procedimiento quirúrgico, ambulatorio o mayor
¿Qué incluye? / Enfocado en: Estudios especializados para diagnóstico y seguimiento de enfermedades crónicas o hematológicas.
¿Cuándo realizarlo? Según indicación médica o seguimiento de tratamiento.
Hematología y coagulación
Estos estudios permiten conocer el estado general de tu sangre, detectar anemias, infecciones, trastornos de coagulación y compatibilidad sanguínea.

¿Para qué sirve? Evalúa glóbulos rojos, blancos y plaquetas. Permite detectar anemias, infecciones o
enfermedades hematológicas.
¿Cuándo realizarlo? Al menos una vez al año como revisión general.
¿Para qué sirve? Determina tu tipo de sangre y factor Rh, necesario para transfusiones o embarazo.
¿Cuándo realizarlo? Solo una vez en la vida, o si se requiere confirmar caso de embarazo o cirugía.
¿Para qué sirve? Evalúan qué tan rápido coagula la sangre; esenciales antes de cirugías o tratamientos.
¿Cuándo realizarlo? Antes de cirugías, tratamientos anticoagulantes o cuando hay sangrados o moretones sin causa.

Química Clínica
Los estudios de química clínica evalúan el funcionamiento de órganos vitales como el hígado, riñones, páncreas y corazón.
¿Para qué sirve? Evalúa glucosa, urea, creatinina y ácido úrico, indicadores clave de riñón y metabolismo.
¿Cuándo realizarlo? Cada 6 a 12 meses o en chequeos generales. Indispensable para diabéticos e hipertensos.
¿Para qué sirve? Incluye los 4 anteriores más colesterol y triglicéridos. Evalúa metabolismo de grasas y función renal.
¿Cuándo realizarlo? Cada 6 meses o cuando existe sobrepeso, colesterol elevado o antecedentes familiares.
¿Para qué sirve? Miden enzimas y proteínas hepáticas para detectar daño o inflamación del hígado.
¿Cuándo realizarlo? En chequeos anuales o cuando se consume alcohol o medicamentos de manera frecuente, o existe un padecimiento de hepatitis.
¿Para qué sirve? Evalúan el equilibrio de sodio, potasio y cloro en sangre, esenciales para corazón y músculos.
¿Cuándo realizarlo? Cuando hay vómito, deshidratación por diarrea, arritmias cardiacas o debilidad.
¿Para qué sirve? Mide colesterol total, HDL LDL y triglicéridos para evaluar riesgo cardiovascular.
¿Cuándo realizarlo? Cada 6 meses o según indicación médica, especialmente si hay antecedentes de colesterol alto.
¿Para qué sirve? Detectan enzimas que indican daño en el músculo cardíaco (como infarto)
¿Cuándo realizarlo? En casos de dolor torácico, fatiga extrema o seguimiento cardiológico.
¿Qué incluye? / Enfocado en: Refleja el control promedio de glucosa durante los últimos 3 meses.
¿Cuándo realizarlo? Cada 3 meses en personas con diabetes o prediabetes.
Inmunología
Los estudios inmunológicos y hormonales permiten evaluar el sistema inmune, el equilibrio hormonal y detectar infecciones virales o bacterianas.

¿Para qué sirve? Evalúa la función de la glándula tiroides. Detecta hipo o hipertiroidismo.
¿Cuándo realizarlo? Cada 6 a 12 meses o ante síntomas como cansancio, aumento de peso o palpitaciones.
¿Para qué sirve? Mide hormonas sexuales (estrógenos, progesterona, testosterona).
¿Cuándo realizarlo? En casos de infertilidad, alteraciones menstruales o disfunción hormonal.
¿Para qué sirve? Evalúa la función del páncreas y resistencia a la insulina.
¿Cuándo realizarlo? Cada 6 meses si hay sobrepeso, prediabetes o antecedentes familiares.
¿Para qué sirve? Detecta alteraciones en la próstata, útil para diagnóstico temprano de cáncer.
¿Cuándo realizarlo? Anualmente a partir de los 45 años o antes si hay antecedentes familiares.
¿Para qué sirve? Indica inflamación infección o activa en el cuerpo.
¿Cuándo realizarlo? En casos de fiebre inflamación seguimiento de tratamientos.
¿Para qué sirve? Detecta infecciones bacterianas graves y sepsis.
¿Cuándo realizarlo? En hospitalización o cuadros febriles severos.
¿Para qué sirve? Evalúa insuficiencia cardíaca o sobrecarga del corazón.
¿Cuándo realizarlo? Cuando hay falta de aire, fatiga o edema.
¿Para qué sirve? Detecta de manera rápida y confiable un embarazo.
¿Cuándo realizarlo? Desde el primer día de retraso menstrual.
¿Para qué sirve? Detecta anticuerpos contra el virus del VIH.
¿Cuándo realizarlo? Cada 6 a 12 meses en chequeos preventivos o antes de cirugía.
¿Para qué sirve? Detecta infecciones por sífilis.
¿Cuándo realizarlo? En chequeos prenatales, donación de sangre o relaciones sin protección.
¿Para qué sirve? Detectan infección o inmunidad contra los virus de hepatitis.
¿Cuándo realizarlo? En chequeos prenatales, transfusiones o antes de cirugía.

Marcadores tumorales
Los marcadores tumorales permiten la detección temprana de ciertos tipos de cáncer, así como el seguimiento de tratamientos oncológicos.
¿Qué incluye? / Enfocado en: Marcador tumoral para detección temprana de cáncer de ovario.
¿Cuándo realizarlo? En mujeres con antecedentes familiares o síntomas ginecológicos persistentes.
¿Qué incluye? / Enfocado en: Marcador tumoral para seguimiento del cáncer de mama.
¿Cuándo realizarlo? En seguimiento médico o sospecha oncológica.
¿Qué incluye? / Enfocado en: Evalúa riesgo de cáncer de hígado o malformaciones fetales
¿Cuándo realizarlo? En embarazo o seguimiento hepático.
¿Qué incluye? / Enfocado en: Marcador general de cáncer, especialmente de colon o pulmón.
¿Cuándo realizarlo? En seguimiento oncológico o antecedentes familiares.
Enfocado en: Marcador tumoral pancreático y digestivo.
¿Cuándo realizarlo? En pacientes con síntomas gastrointestinales o historia familiar
¿Qué incluye? / Enfocado en: Marcador tumoral para cáncer gástrico.
¿Cuándo realizarlo? En casos de gastritis crónica o riesgo oncológico.
Microbiología
Los estudios microbiológicos permiten detectar infecciones urinarias, intestinales o bacterianas que pueden afectar a tu bienestar diario.
¿Para qué sirve? Evalúa el estado de los riñones y vías urinarias, detectando infecciones, proteínas, glucosa o alteraciones metabólicas.
¿Cuándo realizarlo? Cada 6 a 12 meses en chequeos generales o ante síntomas como ardor, dolor o cambios en el color de la orina.
¿Para qué sirve? Detecta parásitos, bacterias o sangre oculta en heces. Útil para identificar infecciones intestinales o trastornos digestivos.
¿Cuándo realizarlo? En casos de diarrea, dolor abdominal o pérdida de peso inexplicable. También como control preventivo una vez al año.
¿Para qué sirve? Identifica bacterias y determina el antibiótico más efectivo para tratarlas.
¿Cuándo realizarlo? Anualmente a partir de los 45 Cuando el médico sospecha infección bacteriana persistente o recurrente
